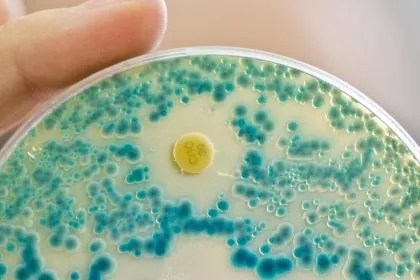

Schweden verbietet Kosmetikprodukte, die Mikroplastik enthalten
Plastik in den Ozeanen ist eines der gravierendsten globalen Umweltprobleme, veröffentlichte die schwedische Umweltministerin Karoline Skog aktuell in einer Regierungserklärung. Um sowohl die Ursachen als auch die Auswirkungen des Problems in den Griff zu bekommen, hat die Regierung Schwedens ein Verbot von Mikroplastik in bestimmten Kosmetika beschlossen.

Hoffnung für Imker: Forscher entdecken Wirkstoff gegen Varroa-Milbe
Forschern der Universität Hohenheim könnte durch Zufall ein langerwarteter Durchbruch im Kampf gegen das Bienensterben gelungen sein. Die deutschen Forscher haben entdeckt, dass Lithiumchlorid möglicherweise ein Heilmittel ist, das ganze Bienenvölker vor der gefährlichen Varroa-Milbe schützen kann.

Riesenschnecken gelangen über Blumenhandel aus Nordamerika nach Europa
Der Blumenhandel importiert auch Schnecken nach Europa, die im Bindegrün mitreisen. Darunter ist auch die bis zu 25 Zentimeter große Bananenschnecke, die in Europa nicht natürlich vorkommt.

Pflanzengifte in einigen Kräuter- und Kamillentees namhafter Hersteller
In sechs von dreizehn gängigen Kräuter- und Kamillentees aus Supermärkten und Discountern wurden Pflanzengifte entdeckt, die zu Leberschädigungen und Leberkrebs führen können.

Wildschwein-Preis im Keller: Teilweise nur 60 Cent pro Kilo
Deutschlands Jäger sind im Schweinezyklus gefangen: Die Preise für Wildschweinfleisch sind wegen des Überangebots im Keller. Nun sollen wegen der drohenden Afrikanischen Schweinepest noch mehr Schweine geschossen werden.

Nistplätze bei geplanten Windrädern werden oft illegal entfernt
In der Nähe von geplanten Windrädern werden immer wieder Greifvögel und ihre Horste beseitigt, erklärt der Naturschutzbund. Seit 2010 wurden über 60 Fälle registriert. Betroffen sind Arten wie Rotmilan, Schreiadler und Mäusebussard.

Wildkatzen vermischen sich in Deutschland nur selten mit Hauskatzen
Wildkatzen und Hauskatzen gehen sich in Deutschland aus dem Weg und paaren sich selten. In Deutschland leben schätzungsweise 5.000 bis 10.000 Wildkatzen und mehr als 10 Millionen Hauskatzen.

Schneechaos: Franzosen sollen ihr Auto stehenlassen
Der Wintereinbruch legt den Verkehr im Norden Frankreichs lahm. Besonders hart wird die Hauptstadt Paris getroffen. Eine Entspannung ist zunächst nicht in Sicht.

Strompreis verharrt auf Rekordhoch
Der Strompreis in Deutschland bleibt für Privathaushalte auf einem Rekordhoch. Ein Vierpersonenhaushalt mit einem Stromverbrauch von 5.000 kWh zahlt offenbar derzeit im Durchschnitt 1.426 Euro pro Jahr.

Wiederansiedlung des Wisent in Deutschland möglich: Spreewald, Müritz, Harz und Pfälzer Wald
„Unter ökologischen Gesichtspunkten gibt es in Deutschland genügend Platz für den Wisent“, sagt Dr. Diana Pretzell, die Leiterin des WWF-Naturschutzes für Deutschland. Die Frage ist, ob die Bevölkerung dies möchte.

Antibiotika-resistente Keime in Gewässern: Experten besorgt
Gesundheitsexperten sind besorgt über antibiotika-resistente Keime in Bächen, Flüssen und Badeseen. "Das ist wirklich alarmierend", so Tim Eckmanns vom Robert Koch-Institut.
Ist das noch Bio? Eierproduzenten halten Zehntausende Legehennen
Der Gedanke an idyllische Hühnerhöfe, wo Bio-Eier im Stroh liegen, ist nicht aus der Welt zu kriegen. Die Wirklichkeit sieht anders aus. Auch Bio-Hennen müssen mit 3000 Artgenossinnen in einem Raum klarkommen. Wenigstens haben sie mehr Platz in Stall und Auslauf.

Anzahl der Wölfe in Deutschland soll verringert werden
Der Schutz der Menschen steht im Vordergrund - die Zahl der Wölfe soll verringert werden, so die Union und SPD. Die AfD sieht hingegen den "dogmatischen" Schutz des Wolfes als Problem. Der Bundestag soll deswegen den Schutzstatus dieses Tieres neu bewerten, so die Forderung.

Reinhold Messner sieht Rückkehr des Wolfes kritisch
Der Südtiroler Extremkletterer Reinhold Messner sieht die Rückkehr des Wolfes nach Deutschland kritisch. Das sei ein großes Problem, zumal das Leben von Schafen nicht weniger wert sei als das Leben von Wölfen.

Nach Tankerunglück vor Chinas Küste: Ölklumpen an japanischen Stränden entdeckt
Fast vier Wochen nach dem Tankerunglück vor der chinesischen Küste sind in Japan Ölklumpen angeschwemmt worden. An Stränden auf mehreren Inseln im Süden Japans seien "öl-ähnliche" Klumpen gefunden worden, heißt es.

Kapstadt trocknet aus: Trinkwasser wird rationiert
Kapstadt rationiert das Trinkwasser auf 50 Liter pro Einwohner täglich. Die Stadtverwaltung fürchtet den "Tag Null", wahrscheinlich am 12. April, an dem die Trinkwasserversorgung zusammenbricht und rund 4 Millionen Einwohner mit Tankwagen versorgt werden müssen.

Starkes Erdbeben versetzt Menschen in Afghanistan, Pakistan und Indien in Angst
Ein schweres Erdbeben hat am Mittwoch Menschen in Afghanistan, Pakistan und Indien in Angst versetzt. Nach Angaben der US-Erdbebenwarte USGS hatte das Beben im Hindukusch-Gebirge eine Stärke von 6,1. In Pakistan starb ein Kind bei einem Dacheinsturz.

Wenig Sonne: Dunkler und warmer Januar
Dunkel, trüb und grau - wer in diesem Januar den Winterblues spürte, muss sich nicht wundern. Nach Berechnung des Deutschen Wetterdienstes fehlte in diesem Monat ein Fünftel des Sonnen-Solls.

Stickoxid-Werte zu hoch: Krisengespräch in Brüssel
Die Autolawine sorgt in vielen deutschen Städten für viel zu schlechte Luft. Die EU-Kommission will dies nicht länger hinnehmen und lädt zum Krisengespräch nach Brüssel. Das sei die letzte Chance, warnt die Brüsseler Behörde.

FDP-Fraktion will Wolf in Deutschland zum Abschuss freigeben
Die FDP will den Wolf abschießen lassen. Der Antrag mit dem Titel "Gefahr Wolf - unkontrollierte Population stoppen" wird am am kommenden Freitag (2. Februar) im Plenum diskutiert.

Chile vergrößert Fläche geschützter Naturparks in Patagonien erheblich
Die chilenische Regierung hat die Fläche geschützter Naturparks in Patagonien erheblich erweitert. Präsidentin Bachelet unterzeichnete ein Dekret, mit dem sich die Zahl der Naturparks um mehr als ein Drittel erhöht.

Umweltverbände fordern harte Linie gegen Deutschland: EU-Grenzwerte für Luftqualität überschritten
Die bisherigen Maßnahmen der Bundesregierung reichten nicht, um die EU-Grenzwerte für Luftqualität einzuhalten, erklärten Umweltverbände. Deswegen solle die EU-Kommission den Druck auf Deutschland erhöhen, forderten sie.
Hochwasser der Seine erreicht Höchststand in Paris
5,84 Meter – das Hochwasser der Seine hat in Paris seinen höchsten Stand erreicht. Ab Dienstag werde es zurückgehen.

Grüne Woche endet nach Besuch von über 400.000 Menschen
Rund 400 000 Menschen haben in diesem Jahr die Internationale Grüne Woche in Berlin besucht. Zehn Tage lang lockte die Agrarmesse mit Nahrungs- und Genussmitteln aus allen Kontinenten in die Messehallen am Berliner Funkturm.

Lebensmittelhändler wollen Plastikverpackungen reduzieren
Nach Plastiktüten versuchen viele Supermärkten jetzt auch Kunststoffverpackungen bei Obst und Gemüse anzuschaffen.

Hochwasser-Alarm in Paris - Tausend Menschen ohne Strom
Im Großraum der französischen Hauptstadt Paris haben bis Freitag fast 400 Menschen ihre Häuser verlassen müssen.

Industrielle Sandwichs so klimaschädlich wie Autoverkehr
Der jährliche landesweite Verzehr von Sandwichs in Großbritannien sei genauso klimaschädlich wie der Autoverkehr, so Forscher der Universität Manchester.

Wintersturm "Friederike” kostet deutsche Versicherer rund eine Milliarde Euro
Der schwere Wintersturm "Friederike" hat Versicherungsschäden von rund einer Milliarde Euro hinterlassen. Er war der zweitteuerste Wintersturm der jüngeren Zeit.

Große Mehrheit junger Deutscher ist umweltbewusst - viele handeln aber nicht danach
Eine große Mehrzahl der jungen Deutschen legt Wert auf eine intakte Umwelt und hält mehr Umweltschutz für notwendig. Doch selbst auf Umweltverschmutzung zu verzichten fällt schwer.

Tausende Menschen nach Überschwemmungen in Paraguays Hauptstadt obdachlos
Überschwemmungen haben in Asunción tausende Menschen obdachlos gemacht. Rund 20.000 Einwohner mussten ihre Häuser verlassen, weil das Hochwasser des Río Paraguay ganze Viertel überflutet, wie die Behörden mitteilten.
